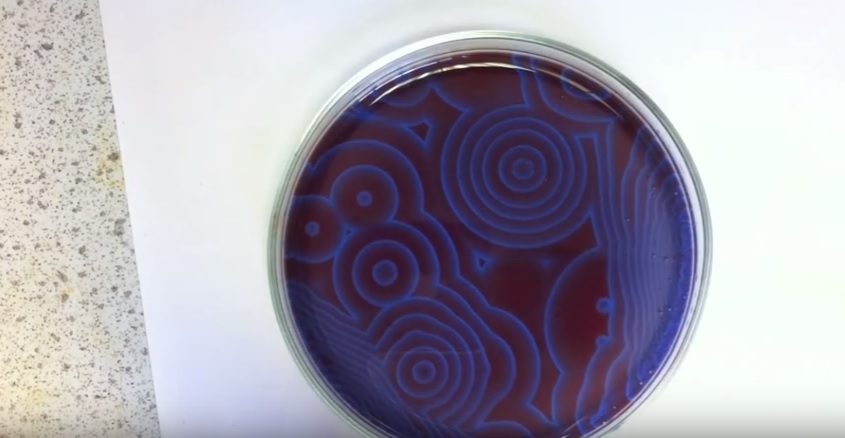

Chemische reacties zijn niet altijd in evenwicht. En dat laat dit filmpje maar al te duidelijk zien.
Lesje scheikunde: wanneer bij een chemisch proces zowel de heengaande als de teruggaande reactie met dezelfde snelheid verloopt dan is die reactie in evenwicht. Maar zoals dat met zoveel dingen in het leven gaat, kunnen ook chemische reacties niet altijd in evenwicht zijn. Positief puntje: scheikundige processen die uit balans zijn, leveren heel mooi beeldmateriaal op:
Belousov-Zhabotinsky-reactie
Wat er in bovenstaand filmpje gebeurt, is een voorbeeld van de Belousov–Zhabotinsky-reactie. Deze reactie is een klassiek voorbeeld van een chemisch proces dat voor de verandering eens niet in evenwicht is.
De chemische reactie wordt versterkt door het product van zijn eigen reactie, een verschijnsel dat autokatalyse wordt genoemd. De BZ-reactie is een autokatalytische reactie, waarin reagerende stoffen – onder invloed van licht – andere stoffen opleveren die op hun beurt dus de productie van de eerste weer bevorderen.
Zelf een BZ-reactie in gang zetten? De ingrediënten voor dit experiment zijn: ferroïne, kaliumbromaat, ammoniumcerium(IV)nitraat en malonzuur. Tja, waar je het vandaan haalt, mag Joost weten, maar het is wel een tof scheikundeproef!
Bronnen: YouTube: The Belousov-Zhabotinsky Oscillating Reaction, Rijksuniversiteit Groningen
 Ben je geïnteresseerd in de wereld van wetenschap & technologie en wil je hier graag meer over lezen? Bestel dan hier ons nieuwste nummer (geen verzendkosten). Abonnee worden? Dat kan hier!
Ben je geïnteresseerd in de wereld van wetenschap & technologie en wil je hier graag meer over lezen? Bestel dan hier ons nieuwste nummer (geen verzendkosten). Abonnee worden? Dat kan hier!